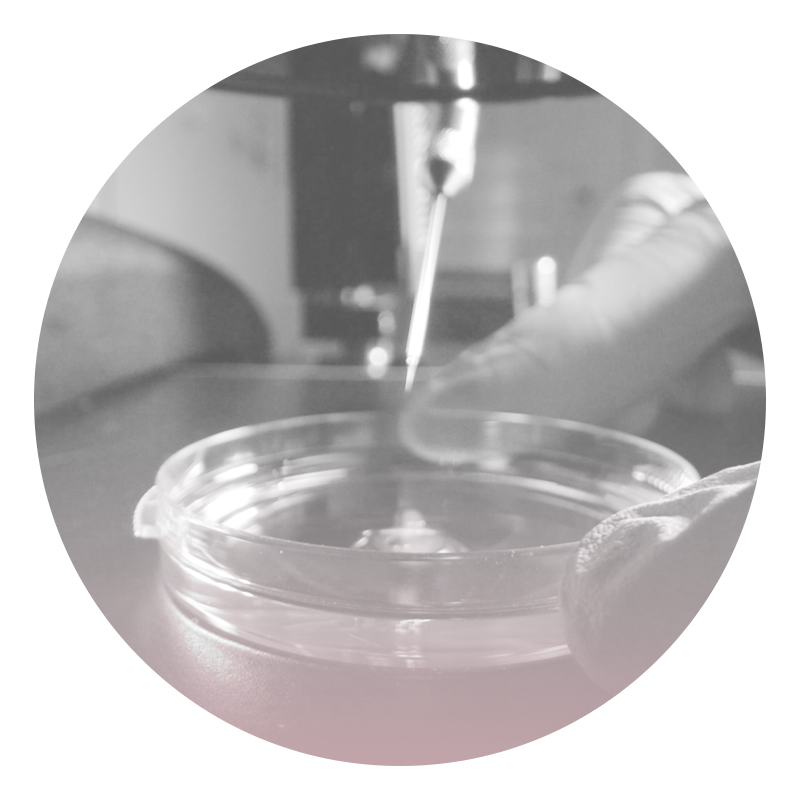

За рождение: ранняя и поздняя беременности
«Если родишь рано — все пройдет идеально», «после 35 родить практически невозможно», «хорошая мама — молодая мама». С такими противоречивыми заявлениями сталкивалась, пожалуй, каждая девушка. Но кто придумал такие тайминги? Почему мы привыкли называть одни роды «ранними», а другие «поздними»? Есть ли у терминов медицинское обоснование или они — результат предрассудков и стереотипов?
В новом проекте «За рождение» PEOPLETALK обсуждает вопросы репродуктивной медицины. Наша цель – развеять стереотипы и с помощью лучших врачей в области акушерства и гинекологии ответить на самые острые вопросы о процедурах ЭКО, ИКСИ, суррогатном материнстве, ранней и поздней беременности. Через истории врачей и их пациентов мы постараемся познакомить тебя с новейшими технологиями в этой сфере.
Для начала стоит обратиться к сухим фактам. Медицински ранней считается беременность от 13 до 19 лет. Согласно статистике, лишь 15% незапланированных ранних беременностей заканчиваются родами. Объяснить это можно несколькими факторами: физиологическими и психологическими. В первом случае, несмотря на то, что организм по биологическим показателям считается молодым и рисков быть не должно, не стоит забывать, что в таком возрасте и репродуктивная, и гормональная система не сформированы до конца, что нередко приводит к осложнениям или угрозам прерывания беременности.
Немаловажную роль играет психологический аспект. Большинство молодых мам могут чувствовать себя оторванными от социума и сверстников, и нередко сталкиваться с непринятием позиции беременеть в таком раннем возрасте. Помимо социальной подоплеки, есть еще и финансовая, поскольку чаще всего подростки финансово зависят от родителей или не имеют самостоятельного и стабильного заработка.
Но даже несмотря на это, не стоит приравнивать раннюю беременность к «неудачной». Все зависит от возможности, окружения и ресурсов, и нередко встречаются примеры счастливых молодых мам, которые активны в жизни своего ребенка и обеспечивают ему счастливое детство.
Поздней же считается беременность после 35 лет. Хотя в современном мире ее уже можно считать нормальной, поскольку все больше женщин осознанно откладывают беременность ради построения карьеры, личной жизни или просто из-за нежелания воспитывать детей раньше 30. Но с таким выбором приходит и ответственность в плане здоровья. После 35 лет начинается постепенное снижение овариального резерва — яйцеклеток становится меньше, и они могут быть менее качественными. От этого увеличивается риск хромосомных отклонений и вырастает возможность врачебного вмешательства в зачатие и роды — кесарево сечение или процедура ЭКО. Но с хорошим врачебным сопровождением и ответственным подходом большинство этих рисков нивелируются.
Так когда стоит рожать? Врачи называют возраст от 20 до 35 самым оптимальным. В этот период организм женщины окончательно формируется и способен выносить ребенка без серьезных осложнений. Мы же считаем, что беременность — не биологический дедлайн. Это история о готовности, поддержке, любви (к себе и к будущему ребенку) и о том, чтобы делать все в свое время. И если «ваше время» наступило — неважно, в 19 или в 39 — значит, оно правильное. И чтобы убедиться в этом, предлагаем тебе посмотреть наш третий выпуск с двумя историями — Кристины и Ольги!